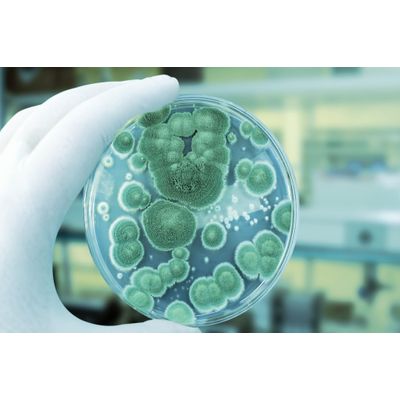

- Home
- Companies
- Rapid Micro Biosystems, Inc.
- Software
- RMBNucleus - Mold Alarm Software
RMBNucleus - Mold Alarm Software
RMBNucleus™ Mold Alarm allows investigations to begin in as little as one day with automated alerts triggered by detection of molds during the early stages of incubation.
- Automated alerts signaling the presence of mold at incubation
- Detection of molds that commonly cause microbial contamination, at temps up to 28°C
- Rapid detection in as little as 1 day
- Enhanced data integrity
- Easy implementation as part of your Growth Direct® System software
New for the Growth Direct® System, RMBNucleus™ Mold Alarm signals at the first sign of mold detection providing real-time results.
Quick to spread and difficult to detect, molds can compromise a facility in the time it takes to confirm their presence. RMBNucleus™ Mold Alarm allows investigations to begin in as little as one day with automated alerts triggered by detection of molds during the early stages of incubation. Qualitative-actionable data is communicated by automated emails and on-screen alerts, providing early intervention and remediation to improve regulatory compliance and reduce safety risks.

Real-time mold detection matters, RMBNucleus™ Mold Alarm signals at the first sign of mold detection. This results in qualitative-actionable data communicated by automated emails and on-screen alerts, providing early intervention and remediation to improve regulatory compliance and reduced safety risks.
Combining automated mold detection with seamless LIMS integration and a full audit trail, RMBNucleus™ Mold Alarm reduces sources of human error while freeing staff from manual data entry. In a study utilizing a panel of 16 commonly recovered EM molds, it detected all molds present.
